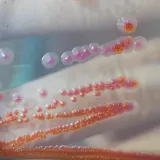
Guba otkrivena u Hrvatskoj, RTL Danas donosi detalje

Kakav nas vikend očekuje nakon što je snijeg zabijelio Gorski kotar, a tuča iznenadila Dalmaciju?
Prognostičari su najavili niske i temperature i kišu za šibensko područje, pa su Šibenčani to danas i očekivali, no tuči koja je pala jutros nitko se nije nadao. Nebo se u jednom trenutku zacrnilo, i nakon nekoliko minuta je krenula i tuča. Iznenađeni građani počeli su trčati i tražili zaklon, a mnogi automobili su se zaustavili jer je od jake tuče vidljivost bila jako loša. Da, kalendarski je proljeće, ali ono zapravo nikako da dođe. U Dalmaciji se još uvijek nose zimske jakne i kaputi, a umjesto sunca eto - tuče. Pogledajte kako je to jutros izgledalo u Šibeniku… A proljeće nije dočekao ni Gorski Kotar gdje su se djeca na proljetnim praznicima sanjkali. Najviše je palo u Begovom razdolju - 12 centimetara.
I za subotu ostajemo u cikloni
A što nas čeka za vikend otkriva metereologinja Damjana Ćurkov Majaroš. "Promjena je uz oblake i obilni kišu gorju donijela i snijeg, a u cikloni ostajemo i tijekom vikenda, pa većih promjena neće biti sutra, ali ovako vrijeme zapravo ostaje i veći dio idućeg tjedna, odnosno prave stabilizacije nema na vidiku.", ističe.
Temperature padaju i do 4 stupnja Celzijevih
Isto za subotu poručuje i DHMZ "U većini krajeva promjenljivo oblačno sa sunčanim razdobljima. Povremeno kiša, a mjestimice može biti pljuskova s grmljavinom, prema kraju dana u Dalmaciji i izraženijih. Vjetar slab do umjeren jugozapadni, u gorju moguće jak. Na Jadranu slabo i umjereno, ponegdje i jako jugo s olujnim udarima, krajem dana na sjevernom dijelu bura. Najniža jutarnja temperatura uglavnom od 4 do 10 °C. Najviša dnevna temperatura između 11 i 16 °C, u Gorskom kotaru i Lici mjestimice malo niža."
Zbog vjetra je za subotu upaljen i žuti meteoalarm za čitavu priobalnu Hrvatsku, od Istre do Dubrovnika.
Nestabilnosti u nedjelju ali i ponedjeljak
U istom tonu proći i nedjelja ali i početak idućeg tjedna.
Na kopnu će nedjelja biti s najviše oblaka, pri čemu ponegdje i još malo svježija, uz umjeren sjeverni i sjeveroistočni vjetar. Početkom tjedna i dalje nestabilno, ali s rjeđom kišom i sunčanim razdobljaima pa će i danju biti toplije, osobito na istoku.", prognozirao je za HRT Izidor Pelajić.